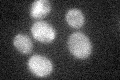
YPL005W

View description
Peripheral mitochondrial inner membrane protein, located on the matrix face of the membrane; stabilizes the bicistronic AAP1-ATP6 mRNA encoding subunits 6 and 8 of the ATP synthase complex
Localization:
Intensity:
Fold change:
Significance:
-
C’ GFP library in SD

below threshold16.59 -
N' NOP1pr-GFP in SD

below threshold24.3975 -
N' TEF2pr-mCherry in SD

below threshold28.9718 -
N' NATIVEpr-GFP in SD

below threshold21.0812 -
N' TEF2pr-VC and Cyto-VN in SD

below threshold21.2228 -
C’ GFP library in SD+DTT

cytosol15.40.92No -
C’ GFP library in SD+H2O2
cytosol18.411.1No -
C’ GFP library in Starvation Media

cytosol15.950.96No -
C’ GFP library on the background of Pup2-DaMP

below threshold -
C’ GFP library on the background of CCT mutant

below threshold15.95490.961211No
